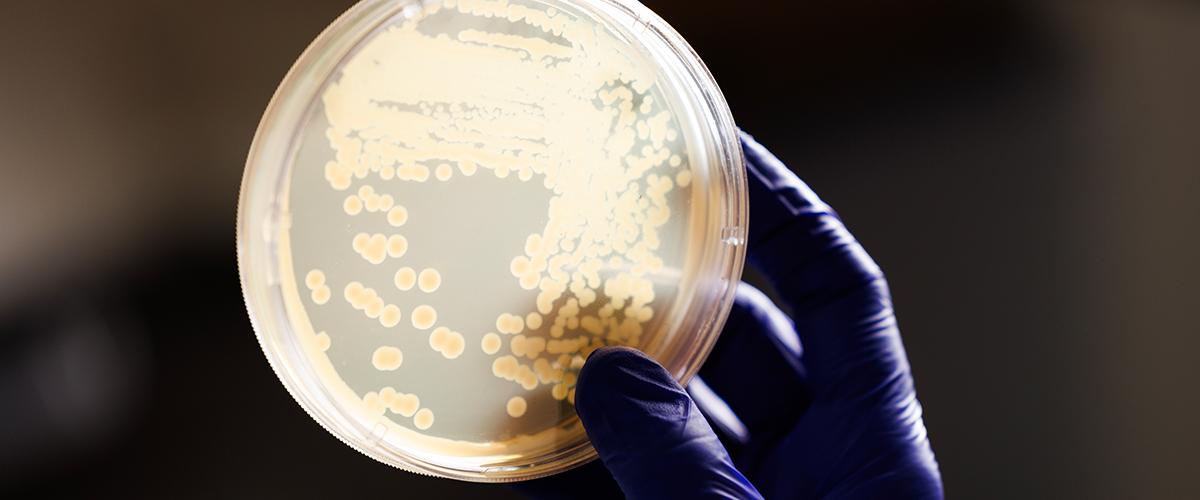
sample from duke peds ID lab

Discover Duke Pediatrics: Advancing Medicine through Innovation!
Duke Pediatrics is internationally renowned for groundbreaking multinational clinical trials, national patient registries, and landmark research. As an academic clinical research organization, we leverage faculty expertise to advance the understanding of health and disease and to improve quality of care. Our work spans basic, translational, and clinical areas and is disseminated through impactful publications and global meetings.